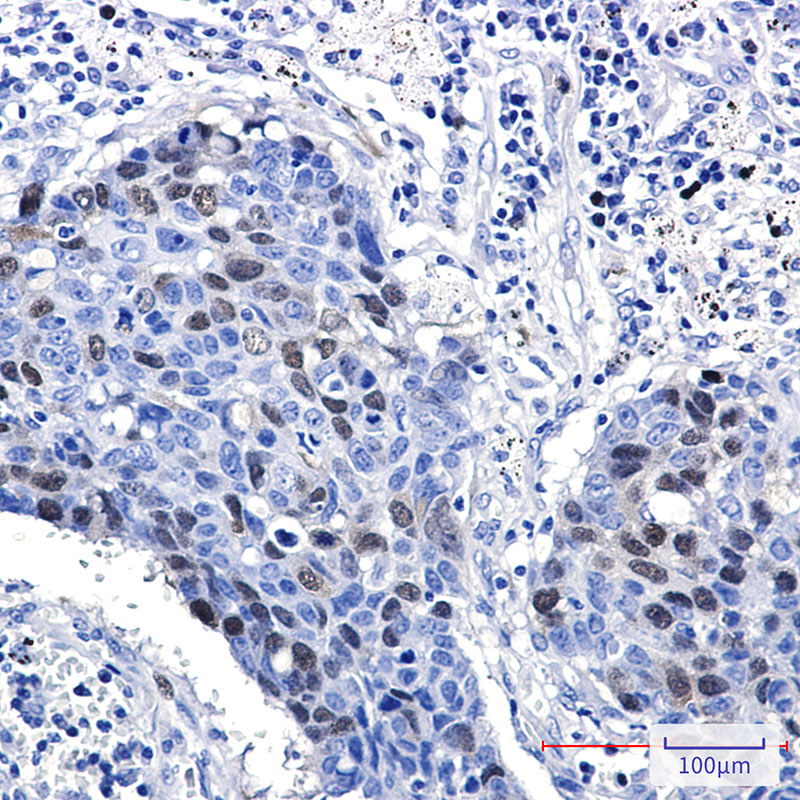

Rabbit Monoclonal Antibody to Cyclin A2
货号:
P21271
别名:
CCN1; CCNA
应用:
WB,IP,IHC,IF
反应种属:
Human
抗体类型:
Primary antibody
Swissprot:
P20248
规格:
目录价
在线咨询
Description |
|---|
The protein encoded by this gene belongs to the highly conserved cyclin family, whose members are characterized by a dramatic periodicity in protein abundance through the cell cycle. Cyclins function as regulators of CDK kinases. Different cyclins exhibit distinct expression and degradation patterns which contribute to the temporal coordination of each mitotic event. In contrast to cyclin A1, which is present only in germ cells, this cyclin is expressed in all tissues Ted. This cyclin binds and activates CDC2 or CDK2 kinases, and thus promotes both cell cycle G1/S and G2/M transitions. |
Specification |
|
|---|---|
| Aliases | CCN1; CCNA |
| Entrez GeneID | 890 |
| Swissprot | P20248 |
| WB Predicted band size | Calculated MW: 49 kDa; Observed MW: 55 kDa |
| Host/Isotype | Rabbit IgG |
| Antibody Type | Primary antibody |
| Storage | Store at 4°C short term. Aliquot and store at -20°C long term. Avoid freeze/thaw cycles. |
| Species Reactivity | Human |
| Immunogen | Recombinant protein of human Cyclin A2 |
| Formulation | Purified antibody in TBS with 0.05% sodium azide,0.05%BSA and 50% glycerol. |
Application |
|
|---|---|
| WB | 1/500-1/1000 |
| IP | 1/10-1/20 |
| IHC | 1/50-1/100 |
| IF | 1/50-1/200 |
Product Image
-
Western blot analysis of Cyclin A2 in Jurkat, Hela lysates using Cyclin A2 antibody.

-
Immunocytochemistry analysis of Cyclin A2 (green) in hela using Cyclin A2 antibody,and DAPI(blue)

-
Immunohistochemistry analysis of paraffin-embedded Human lung cancer using Cyclin A2 antibody.High-pressure and temperature Sodium Citrate pH 6.0 was used for antigen retrieval.

鄂公网安备42018502007531号

